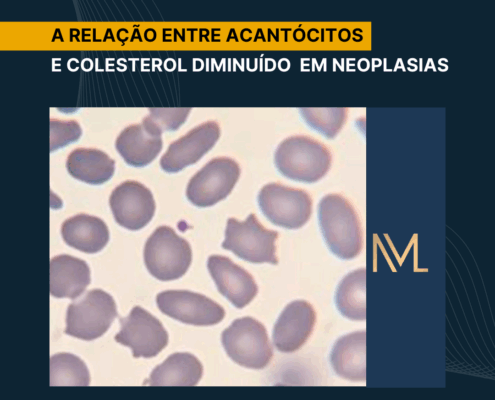

Teste de Coombs Indireto: PAI 1 E PAI 2
O teste de Coombs indireto, também conhecido como teste de antiglobulina indireto, constitui uma técnica fundamental na imunologia aplicada à prática laboratorial, especialmente no contexto de análises clínicas e transfusionais. Ele tem…

Bolsa de sangue irradiada: Fundamentos imunológicos
A transfusão sanguínea desempenha papel crucial em múltiplas situações médicas, contudo, ela acarreta riscos imunológicos significativos, sobretudo a doença do enxerto contra o hospedeiro associada à transfusão (TA-GvHD), na qual…
A relação entre acantócitos e colesterol diminuído em neoplasias
A integração entre a bioquímica e a hematologia representa uma das áreas mais instigantes da medicina laboratorial, pois permite compreender de forma abrangente como alterações metabólicas podem se refletir diretamente na morfologia…

Interferência da Dipirona na Metodologia de Química Seca
A bioquímica clínica desempenha um papel fundamental na prática laboratorial moderna, pois fornece informações essenciais para o diagnóstico, o acompanhamento terapêutico e a prevenção de doenças. Nesse contexto, a escolha da metodologia…

Anemias Carenciais vs. Inflamatórias: Diferenças Laboratoriais
A anemia representa uma das manifestações clínicas mais prevalentes em contextos ambulatoriais e hospitalares, refletindo, frequentemente, desequilíbrios nutricionais, bem como inflamações crônicas ou doenças subjacentes mais complexas.…

Teste de Coombs direto e indireto
Na rotina de um laboratório, os testes de Coombs estão entre os mais importantes da imuno-hematologia. Eles garantem segurança transfusional, bem como ajudam a investigar doenças autoimunes e até protegem recém-nascidos em risco de doença…

Atividade Física Antes da Coleta Sanguínea: Pode Sabotar os Resultados dos Exames Bioquímicos?
Você já ouviu alguém dizer: “Fiz meu treino, tomei meu pré-treino e fui direto pro laboratório fazer os exames”? Essa prática é mais comum do que parece, especialmente, entre pessoas que têm uma rotina intensa de atividade física.…

Coagulograma: O que todo analista clínico precisa saber!
A hemostasia é um processo fundamental do nosso organismo, responsável por equilibrar a fluidez do sangue e a formação de coágulos, especialmente diante de lesões vasculares. Quando esse equilíbrio se perde, o corpo pode desenvolver…

Validação de kits imunológicos
Quando um novo kit imunológico chega ao laboratório, a equipe muitas vezes se pergunta: será que ele realmente entrega o que o fabricante promete? Será que os resultados serão confiáveis no dia a dia da rotina? Será que sempre preciso…

Interferentes analíticos nos testes imunológicos
Você já recebeu um resultado que simplesmente não fazia sentido e, ao repetir o teste, percebeu que não era falha do equipamento ou do kit? Pois bem, muitas vezes, o problema vem dos interferentes analíticos, fatores que, apesar de não…
